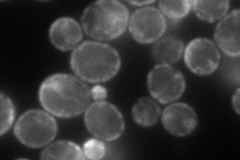
YDL204W
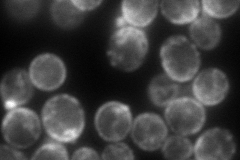
YDL204W
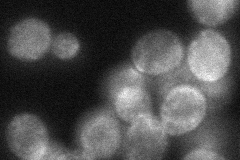
YDL204W
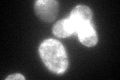
YDL204W
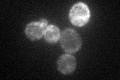
YDL204W
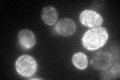
YDL204W

View description
Protein of unknown function; has similarity to mammalian reticulon proteins; member of the RTNLA (reticulon-like A) subfamily
Localization:
Intensity:
Fold change:
Significance:
-
C’ GFP library in SD

ER38.69 -
N' NOP1pr-GFP in SD
cell periphery129.769 -
N' TEF2pr-mCherry in SD
cell periphery,punctate173.285 -
N' NATIVEpr-GFP in SD

below threshold24.0913 -
N' TEF2pr-VC and Cyto-VN in SD
cell periphery,punctate58.6751 -
C’ GFP library in SD+DTT
ER45.321.17No -
C’ GFP library in SD+H2O2
ER56.461.45Yes -
C’ GFP library in Starvation Media
ER110.522.85Yes -
C’ GFP library on the background of Pup2-DaMP

ER -
C’ GFP library on the background of CCT mutant

ER52.43291.35494Yes
